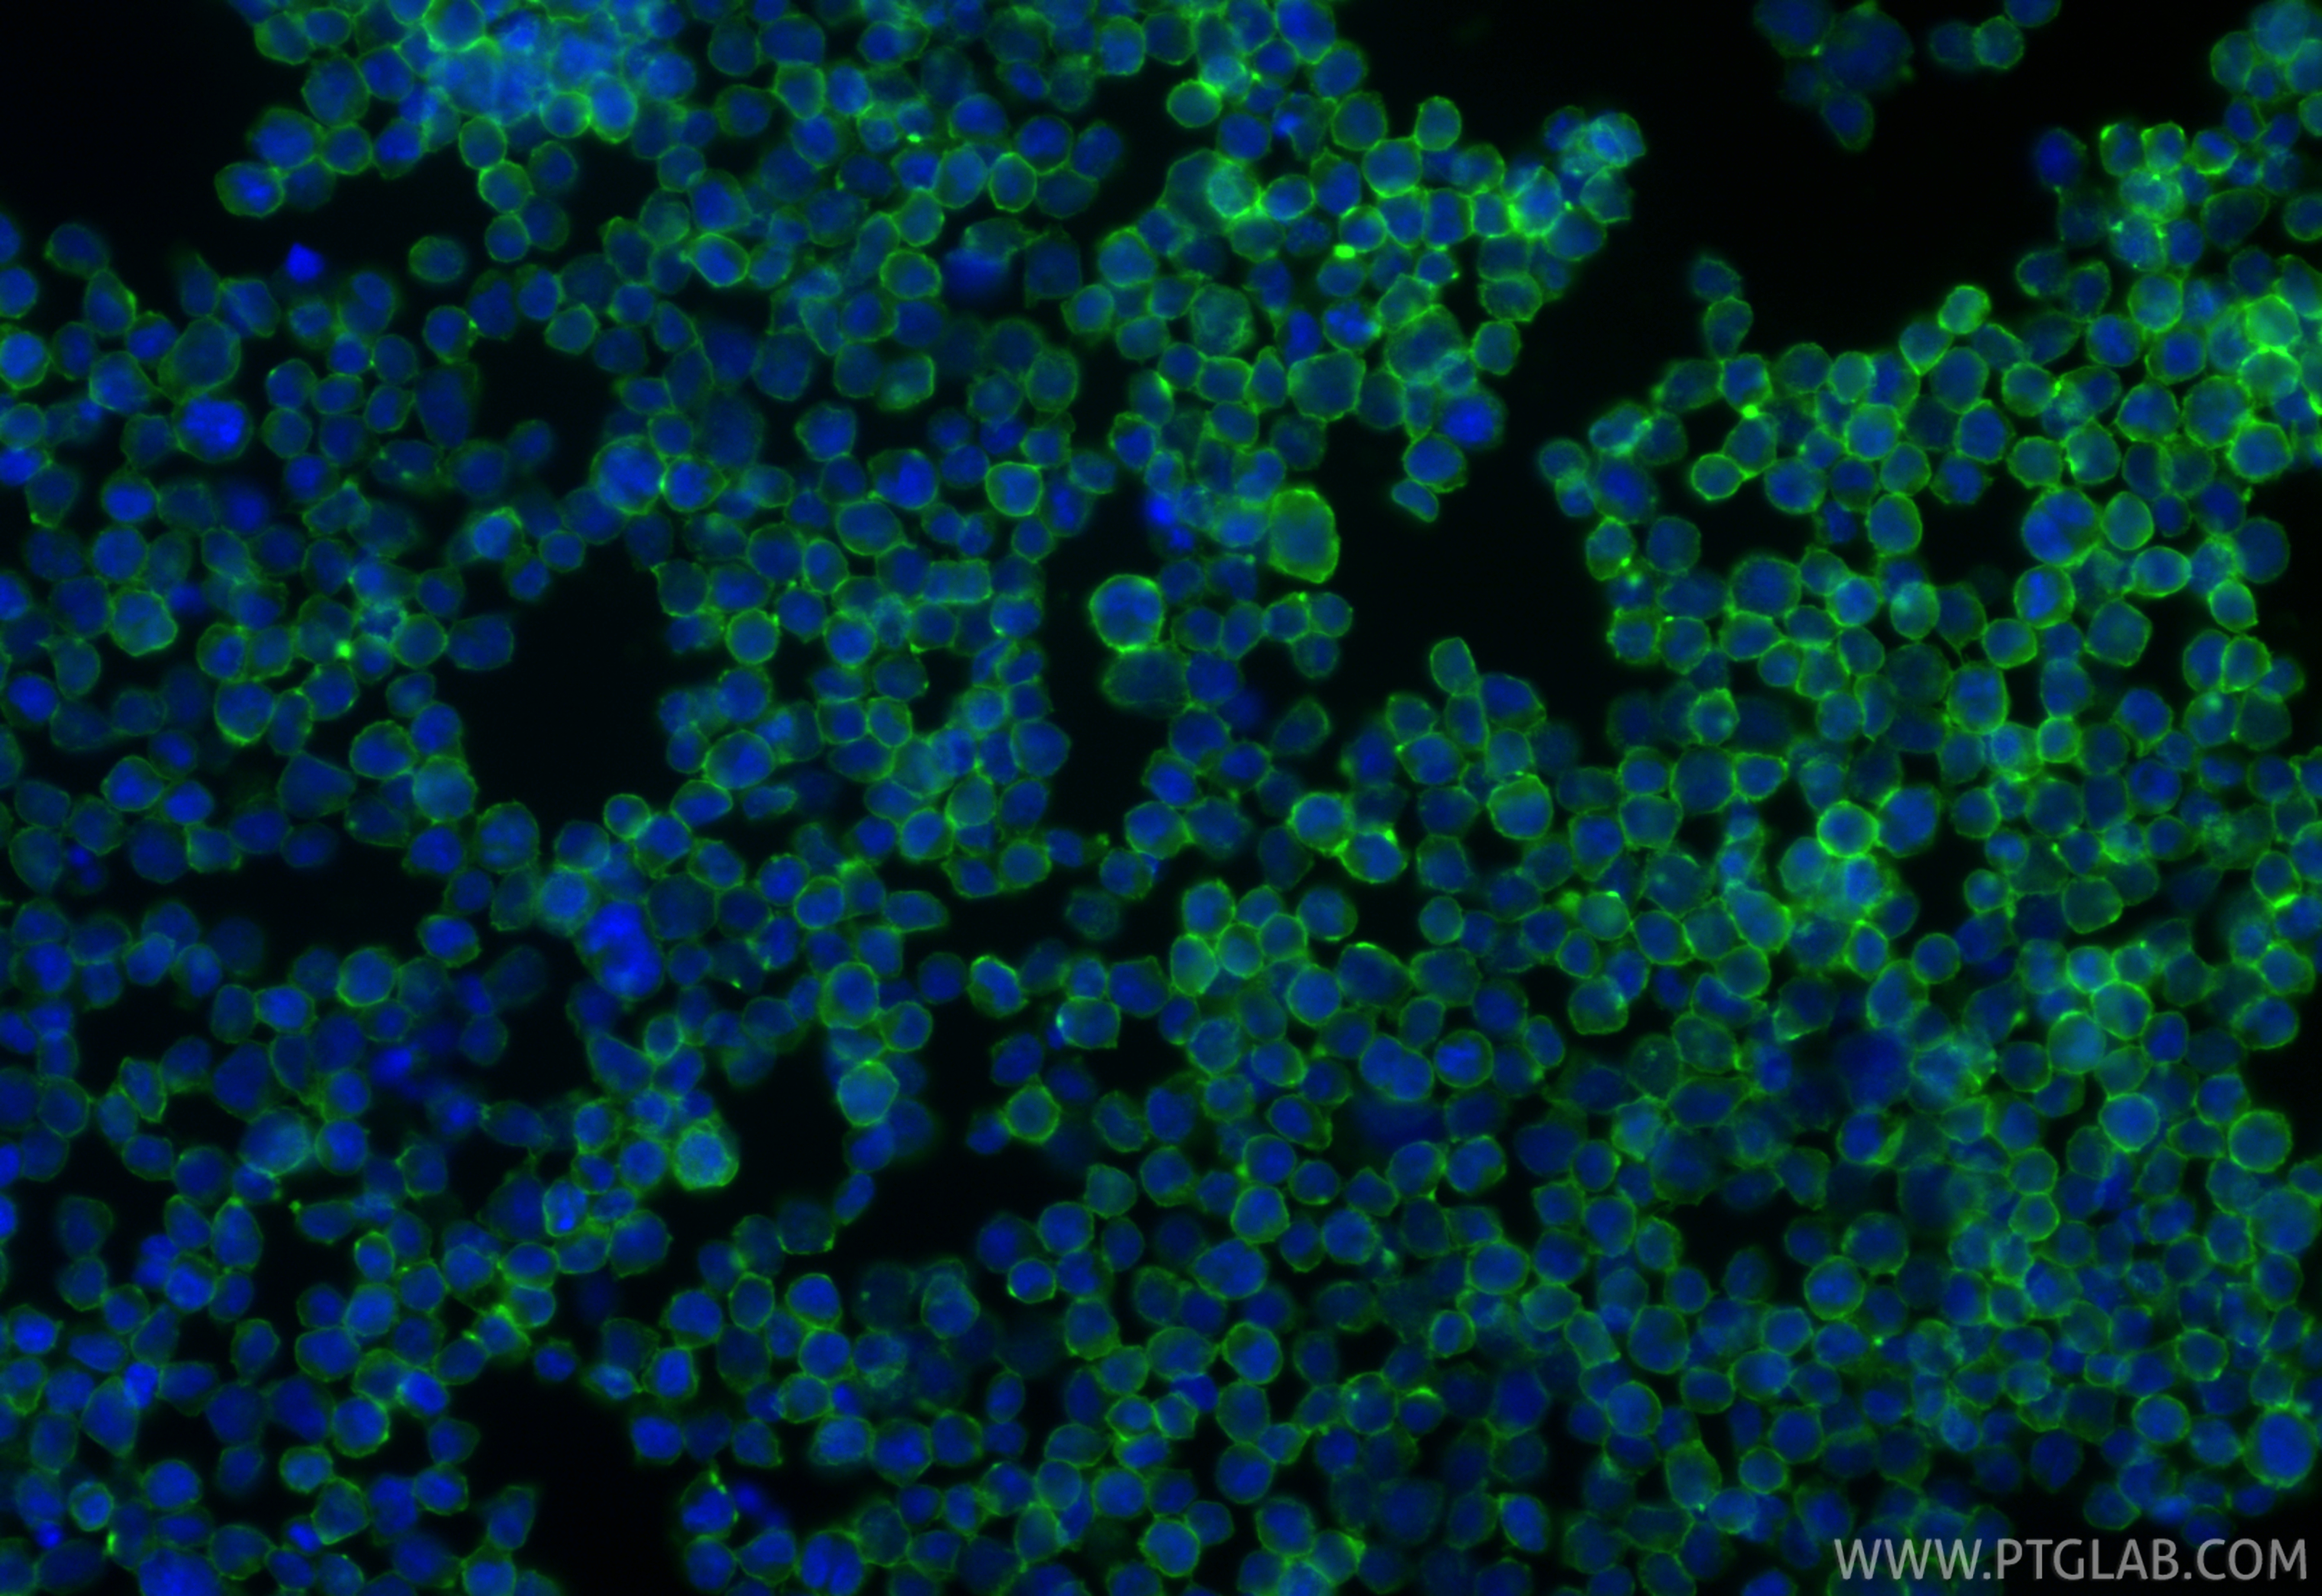
Immunofluorescent analysis of (4% PFA) fixed Jurkat cells using ICAM-2/CD102 antibody (<a class='green' href='/productredirect?CatalogNo=84857-3-RR' target='_blank'>84857-3-RR</a>, Clone: 242237G11 ) at dilution of 1:200 and CoraLite®488-Conjugated Goat Anti-Rabbit IgG(H+L) (<a class='green' href='/productredirect?CatalogNo=SA00013-2' target='_blank'>SA00013-2</a>). This data was developed using the same antibody clone with 84857-3-PBS in a different storage buffer formulation. IF Staining of Jurkat using 84857-3-RR (same clone as 84857-3-PBS)

验证数据展示
产品信息
84857-3-PBS targets ICAM-2/CD102 in WB, IF/ICC, Indirect ELISA applications and shows reactivity with human samples.
| 经测试应用 | WB, IF/ICC, Indirect ELISA Application Description |
| 经测试反应性 | human |
| 免疫原 |
CatNo: Eg2002 Product name: Recombinant Human ICAM2/CD102 protein (rFc Tag) Source: mammalian cells-derived, pHZ-KIsec-C-rFc Tag: C-rFc Domain: 25-223 aa of NM_001099789.2 Sequence: KVFEVHVRPKKLAVEPKGSLEVNCSTTCNQPEVGGLETSLDKILLDEQAQWKHYLVSNISHDTVLQCHFTCSGKQESMNSNVSVYQPPRQVILTLQPTLVAVGKSFTIECRVPTVEPLDSLTLFLFRGNETLHYETFGKAAPAPQEATATFNSTADREDGHRNFSCLAVLDLMSRGGNIFHKHSAPKMLEIYEPVSDSQ 种属同源性预测 |
| 宿主/亚型 | Rabbit / IgG |
| 抗体类别 | Recombinant |
| 产品类型 | Antibody |
| 全称 | intercellular adhesion molecule 2 |
| 别名 | CD102, ICAM2, 242237G11, ICAM 2, ICAM-2 |
| 计算分子量 | 31kDa |
| 观测分子量 | 60 kDa |
| GenBank蛋白编号 | NM_001099789.2 |
| 基因名称 | ICAM2/CD102 |
| Gene ID (NCBI) | 3384 |
| 偶联类型 | Unconjugated |
| 形式 | Liquid |
| 纯化方式 | Protein A purification |
| UNIPROT ID | P13598 |
| 储存缓冲液 | PBS only, pH 7.3. |
| 储存条件 | Store at -80°C. The product is shipped with ice packs. Upon receipt, store it immediately at -80°C |
背景介绍
ICAM2 is a cell adhesion protein having important roles in cell migration, especially during inflammation when leukocytes cross the endothelium. Initially described as a receptor for lymphocyte function-associated antigen-1 (LFA1), ICAM2 may play a role in lymphocyte recirculation by blocking LFA-1-dependent cell adhesion. It mediates adhesive interactions important for antigen-specific immune response, NK-cell mediated clearance, lymphocyte recirculation, and other cellular interactions important for immune response and surveillance. ICAM2 has six N-linked glycosylation sites at amino acids (asparagines) 47, 82, 105, 153, 178 and 187.